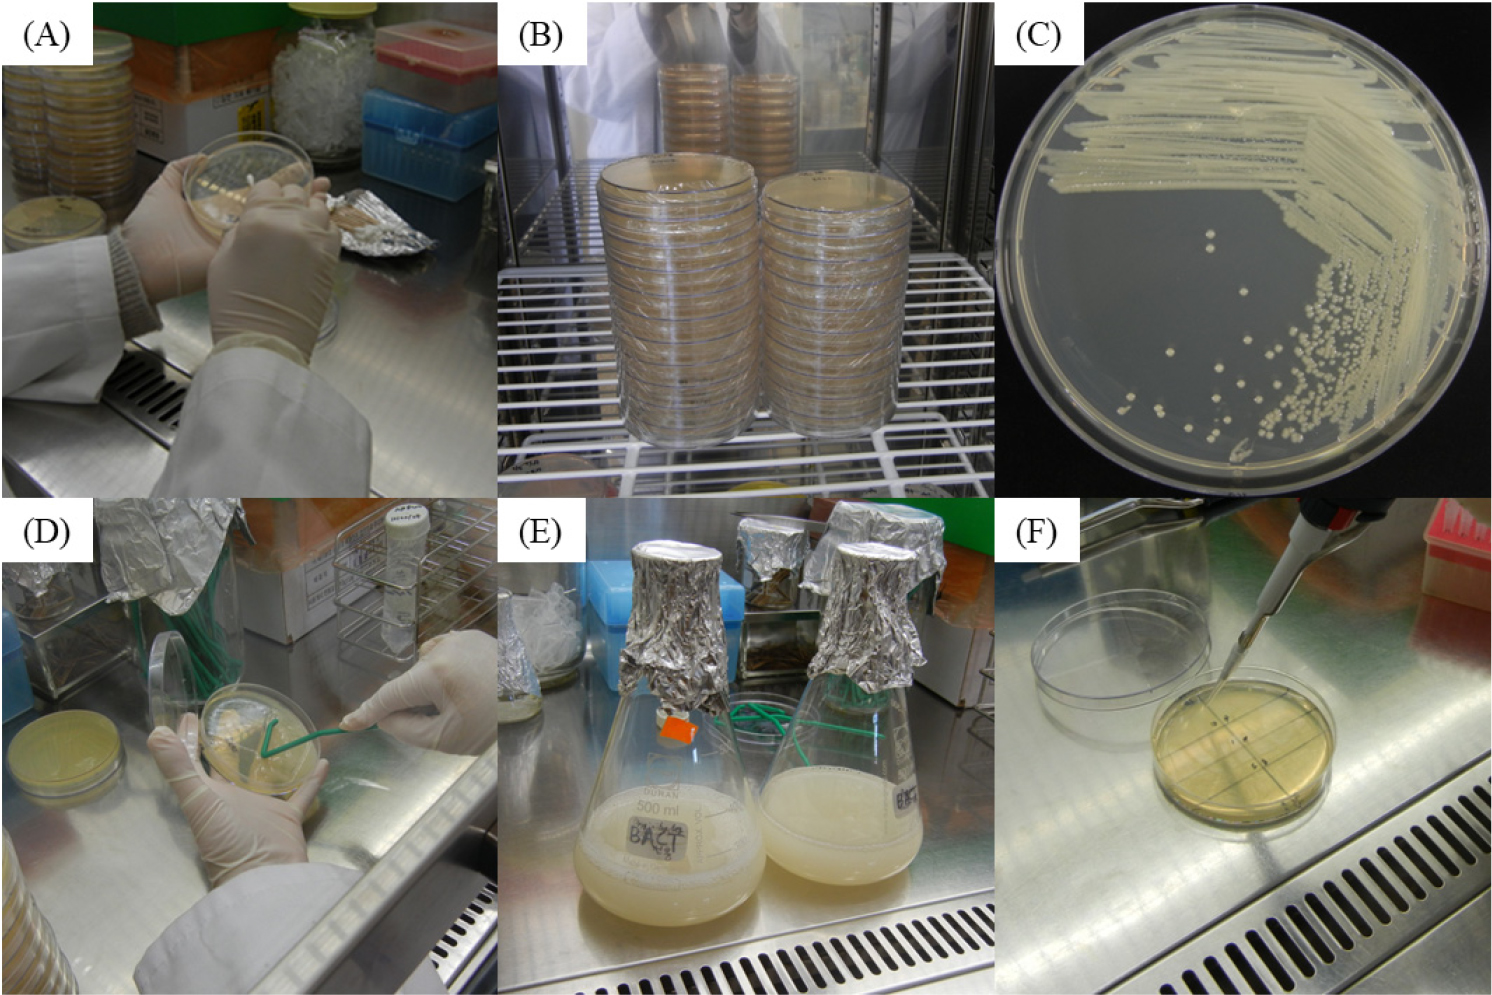
https://cdn.apub.kr/journalsite/sites/phpf/2025-034-03/N0090340307/images/phpf_34_03_07_F1.jpg
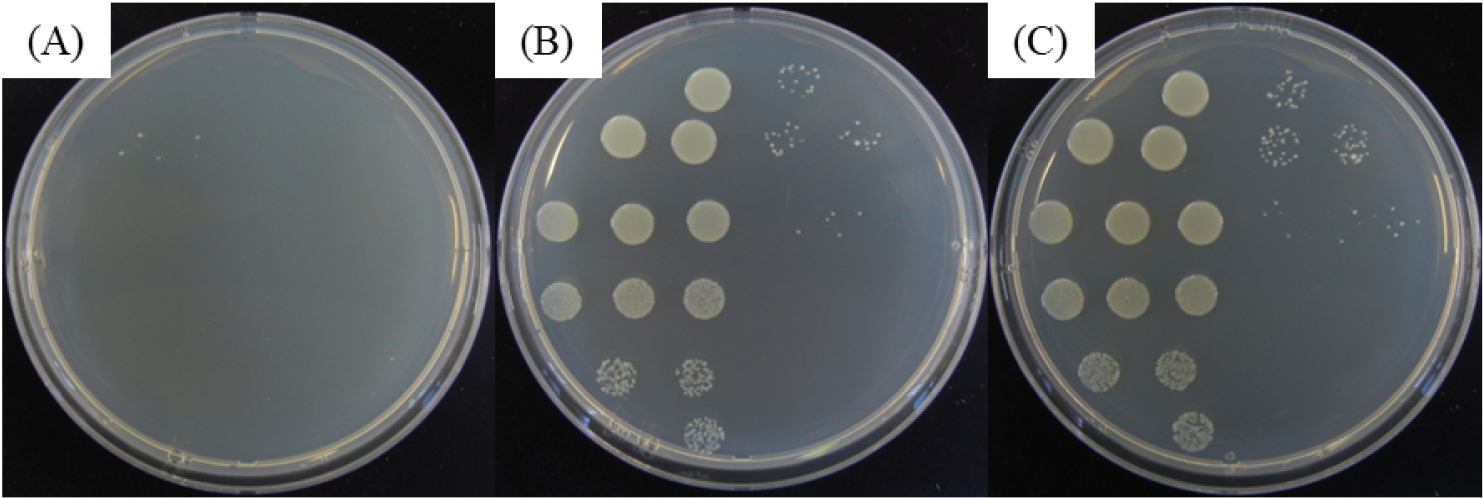
https://cdn.apub.kr/journalsite/sites/phpf/2025-034-03/N0090340307/images/phpf_34_03_07_F4.jpg

서 론
재료 및 방법
1. 병원균 배양 및 생균수 측정
2. 원수 시료 채취 및 UV 처리 시스템
3. 1차 실험: 소비전력-유량 조합에 따른 소독 효과 분석
4. 2차 실험: 고유량 조건에서의 소독 효과
5. Fisher의 정확 검정(Fisher’s Exact Test)
결과 및 고찰
서 론
농업용수는 병원성 미생물에 의해 오염될 수 있으며, 이는 작물 생육 저해 및 생산성 저하로 이어질 수 있다(Ehret 등, 2001; Savvas, 2012). 그중 Agrobacterium rhizogenes는 수염뿌리병을 유발하는 토양 병원균으로, 물을 매개로 하는 전염성이 강한 것으로 보고되어 있다(Bosmans 등, 2017; Fortuna 등, 2023). 순환형 양액 시스템에서는 동일 수원을 반복 사용함으로써 병원균의 확산 가능성이 높아지고, 이에 따른 작물 피해 위험도 증가한다. 이처럼 재순환 수질 관리를 위한 효율적인 소독 기술의 도입은 필수적이며(Ortiz-Solà 등, 2021), 이를 위해 다양한 소독 방법이 제안되어 왔다(Acher 등, 1997).
자외선 소독은 화학제를 사용하지 않고 짧은 접촉 시간 내에 병원체를 효과적으로 비활성화할 수 있으며, 소독 부산물이 남지 않아 환경적 부담이 적고 운영이 간편하다는 장점을 가진다(EPA, 1999; Jang과 Kim, 2005). 특히 UV-C는 파장 100-280nm 범위에 해당하며(KDCA, 2024), 이 중 253.7nm는 병원체 DNA의 이중나선을 손상시켜 복제를 억제하는 데 가장 효과적인 파장으로 알려져 있다(Kowalski, 2009; Sommer 등, 2001). 이러한 작용 메커니즘은 고용량의 UV 처리를 통해 더욱 강화되며(Zhang과 Tu, 2000), 특정 파장에서의 높은 DNA 흡광 특성에 기반한 효율적인 소독이 확인되었고(Vilhunen 등, 2009), UV 처리량이 클수록 살균율은 높아지는 효과가 보고되었다(Lee 등, 2006).
자외선 소독 효과는 수질 내 탁도나 고형물 함량에 의해 제한될 수 있으며, 이는 자외선의 도달 깊이를 감소시켜 소독 효율을 저해하는 요인으로 작용한다(Lee와 Kim, 2019). 그러나 UV-C 소독 성능을 결정짓는 보다 직접적인 요소는 조사 강도와 노출 시간이며, 이는 자외선 시스템의 운전 조건에 의해 크게 좌우된다. 실제로 Bolton과 Linden(2003)은 조사량이 소독 효과를 결정짓는 핵심 인자로 작용하며, 이는 조사 강도와 노출 시간의 곱으로 정의된다고 설명하였다. 저압 수은 UV-C 램프의 방사 강도는 소비전력에 따라 결정되며, 유량은 조사 구간을 통과하는 체류 시간에 영향을 주어 실질적인 조사량을 조절하게 된다. 이처럼 소비전력과 유량은 UV-C 소독 시스템의 설계 및 운전에서 중요한 기준 요소로 작용하며, 소독 성능을 최적화하기 위한 핵심 변수로 간주된다.
UV 살균을 위한 광원으로는 저압 수은램프가 90년 이상 사용되어 왔으며, 현재까지도 상업적 수처리 시스템에서 널리 활용되고 있다(Bergman, 2021). 이 램프는 253.7nm의 단일 파장을 안정적으로 방출하며, 구조적으로 단순하고 비교적 저렴한 비용으로 고출력 소독이 가능하다는 장점을 갖는다. 이러한 시스템은 수경 재배용 양액의 재활용 과정에서도 효과적인 병원균 제어 수단으로 적용 가능하며, 화학 물질이나 유해 폐기물 생성 없이도 경제적 살균이 가능하다는 점이 보고되었다(Tsunedomi 등, 2018).
최근에는 UV-C 기반 광분해 기술이 단순한 병원성 미생물 제거를 넘어, 폐수 내 오염물질 제거에서도 활용 가능성이 제시되고 있다(Pelayo 등, 2023). 그러나 이러한 기술이 발전하는 가운데, 수은 함유 UV 램프의 사용에 대한 규제도 강화되고 있다. 2017년 발효된 미나마타 협약에 따라 수은 제품의 제조와 수출입이 제한되기 시작하면서, 수은 램프의 단계적 폐지 가능성도 논의되고 있다(Minamata Convention on Mercury, 2024). 그럼에도 불구하고, 현재 상용 시스템에서는 여전히 수은램프 기반의 UV 소독 기술이 주로 사용되고 있으며, 이는 대체 기술이 상업적 효율성과 신뢰성 측면에서 아직 충분히 입증되지 않았음을 시사한다(Shah 등, 2021).
본 연구는 저압 수은램프 기반의 UV-C 시스템을 활용하여, 병원성 박테리아인 A. rhizogenes에 대한 농업용수의 살균 효율을 정량적으로 평가하고, UV 램프의 소비전력 조건(40W, 75W, 105W)과 유량 조건에 따른 소독 효과를 비교 분석하는 것을 목적으로 한다. 실험은 1차 실험과 2차 실험으로 구성된다. 1차 실험에서는 서로 다른 소비전력 조건(40W, 75W, 105W)과 유량(10, 15, 30L/min)의 조합을 적용하였고, 2차 실험에서는 소비전력 75W 조건에서 유량을 60L/min과 120 L/min으로 설정하여 고유량 조건에서의 살균 효과를 분석하였다. 각 실험에서 UV 처리 전후의 박테리아 생존율(CFU/mL)을 정량적으로 비교 분석함으로써, 농업 현장에 적용 가능한 효율적이고 환경친화적인 UV 소독 조건을 도출하고자 하였다.
재료 및 방법
1. 병원균 배양 및 생균수 측정
본 실험에 사용된 병원성 박테리아는 rifampicin 저항성 변이주 A. rhizogenes로, Wang 등(2024)의 방법을 참고하여 배양하였다. 균주는 LB 고체배지에 도말한 후 28°C에서 3일간 정치 배양하여 충분히 성장시켰으며(Fig. 1A-C), 이후 멸균 생리식염수로 희석하여 5×109 CFU/mL 농도의 균주 현탁액을 제조하였다(Fig. 1D, E). 제조된 균주 현탁액은 200L의 원수에 접종하여 균일하게 혼합한 후, UV 처리 전후 각각의 조건에서 10mL씩 시료를 채취하였다. 시료는 연속 희석 후 LB 고체배지에 도말하고 28°C에서 48시간 배양하였으며, 형성된 집락 수를 계수하여 CFU/mL로 환산하고, 이를 통해 박테리아 생존율을 정량적으로 비교 분석하였다(Fig. 1F).
Fig. 1.
Preparation and Application Workflow of Agrobacterium rhizogenes in UV Disinfection Experiment: (A) Inoculation onto LB agar plate; (B) Static incubation in incubator at 28°C; (C) Growth of colonies after 3 days; (D) Harvesting of colonies for suspension; (E) Preparation of bacterial suspension; (F) Quantification of viable bacteria after UV treatment using spread plate method.
2. 원수 시료 채취 및 UV 처리 시스템
1차 실험에 사용된 농업용수는 경상남도 사천시 소재 세 농가(A, B, C)에서 각각 지하수 형태로 채취하였으며, 2차 실험에는 경남 함안군 군북면에서 채취한 단일 수원(D)을 사용하였다. 1차 실험은 UV 소독 조건의 일반화 가능성을 평가하기 위한 기초 실험으로, 다양한 수질 조건을 반영한 수원 A-C를 활용하였고, 2차 실험은 고유량 조건에서의 살균 안정성을 분석하기 위한 확장 실험으로 수원 자체의 영향을 배제하고자 수원 D만을 적용하였다. 농업용수의 수질은 경상남도농업기술원에 수질 분석 의뢰를 통하여 확인하였고, 농촌진흥청(RDA, 2020)에서 제시한 양액 재배용 원수 적정 수질 기준(pH 5.0-8.0, EC 0.5dS/m 이하, 주요 이온 농도 등)을 모두 만족하였으며(Table 1), EC, Na, Cl, HCO3⁻ 등 식물 생육에 영향을 주는 주요 항목에서도 기준치 대비 충분히 낮은 수치를 나타내어 본 실험의 대표 수원으로서 적절하였다.
Table 1.
Water quality standards for raw water for facility cultivation and water quality values for each raw water.
| Water source | Water quality values for each raw water | ||||||||
| pH |
EC (dS/m) |
K (mg/L) |
Ca (mg/L) |
Mg (mg/L) |
Na (mg/L) |
Cl (mg/L) |
SO4 (mg/L) |
HCO3 (mg/L) | |
|
Standards (RDA, 2020) | 5.0-8.0 | 0.5 | 10 | 40 | 15 | 30 | 30 | 40 | 100 |
| A point | 7.1 | 0.09 | 0.22 | 4.1 | 1.22 | 14.7 | 1.82 | 10.4 | 42 |
| B point | 7.1 | 0.11 | 1.77 | 10.3 | 2.4 | 8.29 | 10.4 | 5.37 | 26 |
| C point | 6.7 | 0.22 | 1.38 | 24.759 | 5.87 | 16.9 | 18.1 | 11.9 | 89 |
| D point | 6.4 | 0.04 | 0.35 | 1.91 | 0.54 | 5.32 | 1.02 | 6.93 | 18 |
각 수원은 저장탱크(200L)에 보관한 후, 사전에 제조된 A. rhizogenes 균주 현탁액을 접종하여 균일하게 혼합하였다. 혼합이 완료된 수질은 펌프를 통해 UV-C 램프가 장착된 관형 소독 장치를 통과하며 조사되었으며, 조사 후 수질은 수거탱크(200L)로 이동되었다. 시료는 처리 유량이 안정화된 후 수거탱크에서 채취하였으며, UV 조사 전·후의 생균수 비교 분석에 사용되었다. 전체 소독 시스템의 개략적인 구성과 실제 설치된 장비의 모습은 Fig. 2에 나타내었다.

Fig. 2.
Configuration and components of the low-pressure UV-C disinfection system: (A) Flow diagram of the disinfection system from Tank 1 through the pump and UV lamp to Tank 2; (B) Set of three low-pressure mercury UV-C lamps (40 W, 75 W, 105 W) used for the first experiment; (C) Setup used in the second experiment, including the 200 L tanks and the fixed 75 W low-pressure UV-C lamp.
세부 실험 조건 및 이에 대응하는 샘플 번호는 Table 2와 Table 3에 정리하였다. Table 2는 사천시 내 세 농가(A, B, C)의 원수를 대상으로 소비전력(40, 75, 105W)과 유량(10, 15, 30L/min)의 조합에 따라 총 27개의 UV-C 처리 샘플을 구성한 1차 실험 조건을 나타낸다. 이와 함께, 샘플 #10, #20, #30은 각 수원별로 접종 직후 채취된 시료로서, 균주가 수원 내에 정상적으로 혼합되었는지를 확인하는 대조 시료로 활용되었다. Table 3은 함안군 군북면의 원수(D)를 사용한 2차 실험 조건으로, 소비전력 75W 하에 유량을 60 및 120L/min으로 설정하였으며, 샘플 #37과 #38은 각각의 유량 조건에 대해 UV-C 처리 전 상태의 접종 확인 및 생균수 초기 농도 검증을 위한 대조 시료로 사용되었다.
3. 1차 실험: 소비전력-유량 조합에 따른 소독 효과 분석
1차 실험은 저압 수은 UV-C 시스템의 소비전력 조건(40W, 75W, 105W)과 유량 조건(10, 15, 30L/min)의 상호작용이 병원성 박테리아 Agrobacterium rhizogenes의 살균 효과에 미치는 영향을 정량적으로 분석하고자 수행되었다. 실험 설계는 소비전력과 유량의 3×3 요인 조합으로 구성되었으며, 총 9개의 처리 조건을 각각 수원 A, B, C에 적용하여 총 27개의 실험군을 마련하였다.
실험은 수원 A부터 시작하여, 유량을 10L/min으로 고정한 상태에서 세 가지 소비전력 조건을 순차적으로 적용하고, 이후 유량을 15L/min 및 30L/min으로 변경하여 동일한 전력 조건을 반복 적용하는 방식으로 진행되었다. 동일한 절차를 수원 B와 C에도 각각 반복하였으며, 처리된 원수는 수거탱크로 회수한 후 시료를 채취하여 생균수를 분석하였다. 각 수원별 접종 직후 채취된 샘플(#10, #20, #30)은 균주 혼합 상태를 검증하기 위한 대조 시료로 활용되었다. 실험 조건 및 샘플 번호는 Table 2에 정리하였다.
Table 2.
Experimental conditions and corresponding sample numbers for low-pressure UV-C disinfection (1st experiment).
조사강도는 UV 램프의 정격 소비전력을 기준으로 설정되었으며, 실제 조사량은 램프의 자외선 방출 효율(약 30조절40%)을 고려하여 간접적으로 해석하였다(Bolton과 Linden, 2003). 한편, 유량은 UV 조사 구간의 체류 시간과 조사량을 결정하는 핵심 변수로 작용하며, 유량이 증가할수록 박테리아의 자외선 노출 시간이 감소하게 된다. 실제 수치모사 연구에서도 유량 증가가 조사량의 평균값을 낮은 영역으로 이동시킨다는 결과가 제시된 바 있다(ULTRAAQUA, 2024; Li 등, 2017). 본 실험은 이러한 기초 이론을 바탕으로 소비전력–유량 조합에 따른 실효 조사량의 확보 가능성과 살균 안정성을 평가하고자 하였다.
4. 2차 실험: 고유량 조건에서의 소독 효과
2차 실험은 실제 농업 현장의 대용량 급수 환경을 반영하여, UV-C 소독 시스템이 고유량 조건에서 어느 수준까지 안정적인 살균 성능을 유지할 수 있는지를 평가하고자 수행되었다(Zhu et al., 2002). 실험에는 수원 D를 사용하였으며, 소비전력은 1차 실험 결과를 바탕으로 조사강도와 에너지 효율 간 균형을 고려하여 75W로 고정하였다. 이는 40W 대비 충분한 조사 강도를 확보할 수 있으면서도, 105W에 비해 상대적으로 낮은 에너지 소비로 실험 조건을 통제할 수 있다는 점에서 선정되었다.
이후 유량을 60L/min 및 120L/min으로 설정하고, 각 조건에서 3회 반복 실험을 수행하였다. UV 처리가 완료된 시료는 수거탱크에서 채취하였으며, 처리 전 접종 상태 확인을 위해 각 유량 조건에 대응하는 대조 시료(#37, #38)도 함께 분석하였다. 세부 실험 조건은 Table 3에 정리하였다.
Table 3.
Experimental conditions and corresponding sample numbers for low-pressure UV-C disinfection (2nd experiment – high-flow condition).
| Flow rate (L/min) | Lamp power consumption (75 W) – Sample no. | ||
| 60 | #31 | #32 | #33 |
| 120 | #34 | #35 | #36 |
고유량 조건에서는 조사 구간을 통과하는 시간이 짧아지기 때문에, 박테리아가 자외선에 노출되는 시간이 제한되고, 결과적으로 조사량 확보가 어려워질 수 있다. 이러한 상황은 조사량 부족으로 인한 불완전 살균의 가능성을 높이며, 시스템 성능의 한계로 작용할 수 있다. 본 실험은 이러한 제한 조건에서도 안정적인 소독 효과가 유지되는지를 검토하고, UV-C 소독 시스템의 운전 유연성과 현장 적용 가능성을 실험적으로 평가하고자 하였다.
5. Fisher의 정확 검정(Fisher’s Exact Test)
본 연구에서는 실험 결과의 통계적 분석을 위해 Fisher의 정확 검정을 적용하였다. 이 검정은 두 범주형 변수 간의 독립성을 평가하는 비모수 검정으로, 특히 샘플 수가 적거나, 기대빈도가 낮은 경우에도 신뢰도 높은 결과를 제공하는 통계 방법이다(Kim, 2017). 본 실험은 각 처리 조건에서 반복 수가 제한적(n = 3)이며, UV 처리 여부에 따라 박테리아가 ‘검출됨’ 또는 ‘검출되지 않음’으로 나뉘는 이분형 결과를 도출하기 때문에, 전통적인 카이제곱 검정보다 Fisher의 정확 검정이 적합한 통계 분석 방법으로 판단되었다. 특히, 이 검정 방법은 2×2 형태의 분할표를 구성하여 각 처리 조건 간 박테리아 검출률의 차이를 분석하는 데 효과적이다. 검정은 귀무가설을 “두 조건 간에 박테리아 검출률의 차이가 없다”로 설정하고, 유의수준 0.05를 기준으로 수행되었다. 본 방법은 소규모 생물학 실험에서 처리 효과의 유의성을 검증하는 데 널리 활용되며, 본 연구에서도 UV 소독 조건 간 효과 비교의 정량적 판단 근거로 사용되었다.
결과 및 고찰
1차 실험에서는 저압 수은 UV-C 소독 시스템의 소비전력 조건(40, 75, 105W)과 유량 조건(10, 15, 30L/min)을 3×3 조합으로 실험을 구성하여 A. rhizogenes에 대한 살균 효과를 평가하였다. 실험 결과, 각각의 대조군을 제외한 모든 조합(총 27개 처리구)에서 박테리아가 검출되지 않았으며, 전 구간에서 완전한 사멸이 확인되었다(Fig. 3). 특히 소비전력이 가장 낮고 유량이 가장 높은 조건(40W-30L/min)에서도 검출이 없었다는 점은, 상대적으로 낮은 에너지 소비 조건에서도 충분한 UV 조사량이 확보된다면 안정적인 소독 효과가 발현될 수 있음을 시사한다. 이는 불활성화 곡선 기반 모델에 따라 UV 조사량과 박테리아 사멸률 사이의 지수적 관계를 제시한 Hijnen 등(2006)의 기존 연구와도 일치하는 결과이다.

Fig. 3.
UV-C disinfection results from 1st experiment (samples #1–#10, water source A). Not detected in UV-treated samples (#1–#9); visible colonies observed in untreated control (#10).
zThe same inactivation pattern was observed for water sources B and C. Samples #11–#19 and #21–#29 showed no detectable growth, and controls (#20, #30) confirmed successful inoculation prior to disinfection.
저압 수은 UV-C 램프는 일반적으로 약 30-40%의 전력을 254nm 파장의 자외선으로 전환하는 것으로 알려져 있으며, Zhang 등(2013)의 연구에 의하면 최적 조건에서는 최대 46%까지의 방사 효율이 보고된 바 있다. 또한 van der Meer 등(2018)은 고출력 조건에서도 아말감 램프가 일정한 방사 효율을 유지함을 확인하였다. 따라서 소비전력은 조사강도의 간접적 지표로 활용될 수 있으며, 이러한 결과는 실험실 수준의 장치에서도 비용 효율적인 소독 시스템 구축이 가능함을 보여준다. 나아가 본 기술은 농업용 순환 수경재배 시스템 내 병원균 확산 방지 및 수질 안정화를 위한 실용적 소독 기술로의 적용 가능성을 보여준다. Dotson 등(2012)은 미국 내 여러 정수장에서 UV-C 소독이 농업 및 하수 유입 등으로 오염된 원수에 효과적인 1차 소독 장치로 활용되고 있음을 보고하였으며, 이는 본 연구 결과의 실용적 확장 가능성을 뒷받침한다.
2차 실험은 고유량 조건에서의 실효 소독 성능을 확인하기 위해 소비전력 75W 조건을 고정하고, 유량을 60L/min과 120 L/min으로 설정하였다. 실험 결과, 120L/min 조건에서는 세 샘플 모두에서 박테리아가 검출되지 않았으며, 60L/min 조건에서는 단 한 샘플(#33)에서만 2.0×102CFU/mL의 박테리아가 검출되었다(Fig. 4, Table 4). Fisher의 정확 검정 결과 두 처리 간 p-value는 0.5로 나타났으며, 이는 통계적으로 유의한 차이가 없다는 것을 의미한다(Table 5). 이는 유량 변화가 살균 효과에 유의미한 영향을 미치지 않으며, 일정 수준 이상의 조사량이 확보되면 고유량 조건에서도 안정적인 살균 효과가 유지될 수 있음을 시사한다. 이는 Kumar 등(2021)의 연구에서, 서로 다른 조사 강도에서도 동일한 누적 조사량이 확보되면 유사한 수준의 살균 효과가 나타난다는 결과와도 일치한다. 이러한 결과는 다양한 유량 및 소비전력 조건에서도 UV-C 소독이 실용적인 효과를 가질 수 있음을 시사한다. Perez 등(2024)은 5W 저압 수은 UV-C 램프와 6.7L/min의 저유량 조건에서도 폐쇄형 수경 배양액 내 병원성 박테리아를 효과적으로 억제하고 식물 생육을 개선할 수 있음을 입증하였다. 또한, Science in Hydroponics(2017)는 상업용 순환 수경 시스템에서 18W 인라인 UV 램프를 통해 약 47L/min 조건에서도 안정적인 병원균 제어가 가능함을 보고한 바 있다. 본 연구의 120L/min 조건에서의 완전 사멸 결과는, 이러한 선행 사례들과 비교할 때 현저히 높은 유량 조건에서도 UV-C 시스템의 안정적인 성능이 유지될 수 있음을 의미하며, 소비전력–유량 조합의 운전 최적화를 통해 에너지 효율성과 처리량을 동시에 향상시킬 수 있음을 실증한 결과라 할 수 있다.
Table 4.
Summary of UV-C disinfection results and control CFU/mL counts (1st and 2nd experiments).
Table 5.
Bacterial detection outcomes under high-flow UV-C treatment and statistical analysis using fisher’s exact test.
| Flow rate (L/min) | Bacteria detected (count) | Not detected (count) | Total (count) |
| 60 | 1 | 2 | 3 |
| 120 | 0 | 3 | 3 |
| Total | 1 | 5 | 6 |
Fig. 4.
Representative UV-C disinfection outcomes under high-flow conditions (75 W, 60-120 L/min): (A) Sample #33 (UV-treated, 60 L/min); (B) Sample #37 (untreated control, 60 L/min); (C) Sample #38 (untreated control, 120 L/min).
zAll other treatment conditions in the second experiment showed complete inactivation of Agrobacterium rhizogenes, with no detectable bacterial growth.
본 실험에서는 대부분의 처리 조건에서 박테리아가 완전히 검출되지 않았으며, 60L/min 조건에서도 단 1회만이 극히 낮은 수준(2.0×102CFU/mL)의 검출 결과를 나타냈기 때문에, 박테리아의 존재 여부 자체를 기준으로 이분형 자료를 구성하고 Fisher의 정확 검정을 적용하는 것이 통계적으로 더 적절하다고 판단하였다. 이는 박테리아 검출 여부가 실용적 살균 기준에서의 핵심 지표로 기능한다는 점에서, 실제 적용 가능성을 고려한 분석 방식이라 할 수 있다.
60L/min 조건에서 유일한 검출이 발생한 것은 시스템 운용 및 설계와 요인에 의해 발생했을 가능성이 있다. Paidalwar와 Khedikar(2016)는 유량 증가로 인한 체류시간 감소가 조사량 확보에 부정적 영향을 미쳐 불활성화 효율이 저하될 수 있다고 보고하였으며, Sigge 등(2023)은 실제 농장 환경에서 자외선 조사 음영, 흐름의 비균일성, 표면 오염 등으로 인해 국소적 미살균 영역이 발생할 수 있음을 지적하였다. Hwang 등(2024)은 수질 내 탁도 및 고형물 함량이 자외선 투과도를 크게 저하시켜 소독 효율에 영향을 줄 수 있다고 보고하였다. 이는 본 실험에서 일부 영역에서의 조사량 부족이 검출 발생의 원인일 수 있음을 시사한다. 해당 조건의 대조군(#37)에서 1.6×107CFU/mL가 검출된 반면, UV 처리된 샘플(#33)에서는 2.0×102CFU/mL로 약 4.9log 수준의 생균수 감소가 확인되었으며, 이는 전반적으로 안정적인 소독 효과가 유지되었음을 보여준다. 향후 유사 조건에서도 안정적인 소독 효과를 확보하기 위해서는 조사량의 불균일성이나 센서 오차 등의 리스크에 대한 보정이 설계 단계에서 적절히 고려되어야 한다. 미국 환경청(EPA, 2006)은 이러한 미살균 가능성을 반영하여 Validation Factor(VF) 개념을 도입하고 있으며, 이는 실험에서 확보된 조사량보다 실제 운전 시 더 높은 조사량을 요구하도록 보정하는 계수이다. 따라서 실증 시스템 설계 시에는 VF를 반영한 여유 운전 기준이 함께 고려되어야 한다.
본 연구는 UV-C 소독 시스템의 주요 운전 변수인 소비전력과 유량 간의 상호작용을 정량적으로 분석함으로써, 효과적인 조사량 확보를 위한 운전 조건의 임계 범위를 실험적으로 제시하였다. 고유량 조건에서도 일정 수준 이상의 소독 효과가 유지된다는 결과는 조사량의 최소 임계치를 만족하고 있다는 해석이 가능하며, 이는 램프 출력 대비 유량 최적화를 통해 에너지 효율 향상 가능성을 시사한다. 특히 40W와 같은 저소비전력 조건에서도 유량과의 적절한 조합을 통해 완전한 소독이 가능하다는 점은, 단순한 비용 절감을 넘어 에너지 사용의 효율성 측면에서도 중요한 의미를 가진다. 이와 관련하여, 미국 환경청(EPA, 2006)은 병원성 미생물 제어를 위한 최소 소독 기준으로 3log 이상의 감쇄 수준을 제시하고 있으며, Banach 등(2021)은 농업용 수처리에서 2-3log 수준의 감쇄를 실질적인 소독 효과로 간주하였다. 본 연구에서 확인된 4.9 log 수준의 생균수 감소는 이 기준을 상회하는 수준으로, UV-C 기술이 수경재배와 같은 폐쇄형 농업 시스템에서도 충분한 실용성과 신뢰도를 가질 수 있음을 입증한다.
이와 같은 분석을 바탕으로 볼 때, 저압 수은 UV-C 기술은 고정식 수경 시스템이나 수처리 부하가 큰 농업 환경에서도 실질적인 대안으로 적용될 수 있다. 다만, 실제 농업 현장에서는 UV-C 기술의 장점에도 불구하고 채택이 원활하지 않은 실정이다. Haley 등(2024)은 UV-C 기술이 효과적인 수처리 대안임에도 불구하고, 생산자들은 초기 비용, 기술적 숙련도 부족, 그리고 정보 접근성 부족으로 인해 이를 실제로 도입하지 못하고 있다고 보고하였으며, 이러한 장벽을 극복하기 위한 실증 기반의 전략 마련이 요구된다.
향후 연구에서는 탁도, 유기물, 고형물 등 수질 인자는 물론, 장기 운용에 따른 램프 효율 저하, 자동화 제어 시스템과의 연계 가능성 등을 통합적으로 고려한 기술 검증이 필요하다. 본 연구는 실험실 수준에서 소비전력–유량 조건 조합에 따른 UV-C 소독 효율을 정량적으로 제시한 기초 자료로서, 향후 실증 시스템 설계 및 현장 맞춤형 자동화 기술 개발을 위한 기반 자료로 활용될 수 있을 것으로 보인다. 또한, 본 실험에서 도출된 살균 효율 데이터는 실제 농업 환경에서의 UV-C 시스템 적용 가능성을 검토하는 데 있어 실용적 근거로 작용할 수 있으며, 수처리 부하와 에너지 소비 간 균형을 고려한 운전 전략 수립에도 활용될 수 있다. 특히 40W와 같은 저전력 조건에서도 고유량 처리가 가능하다는 점은, 대규모 순환 수경 시스템 또는 폐쇄형 재배 환경에서도 UV-C 기술의 적용성을 높이는 중요한 지표로 기능할 것으로 기대된다.


